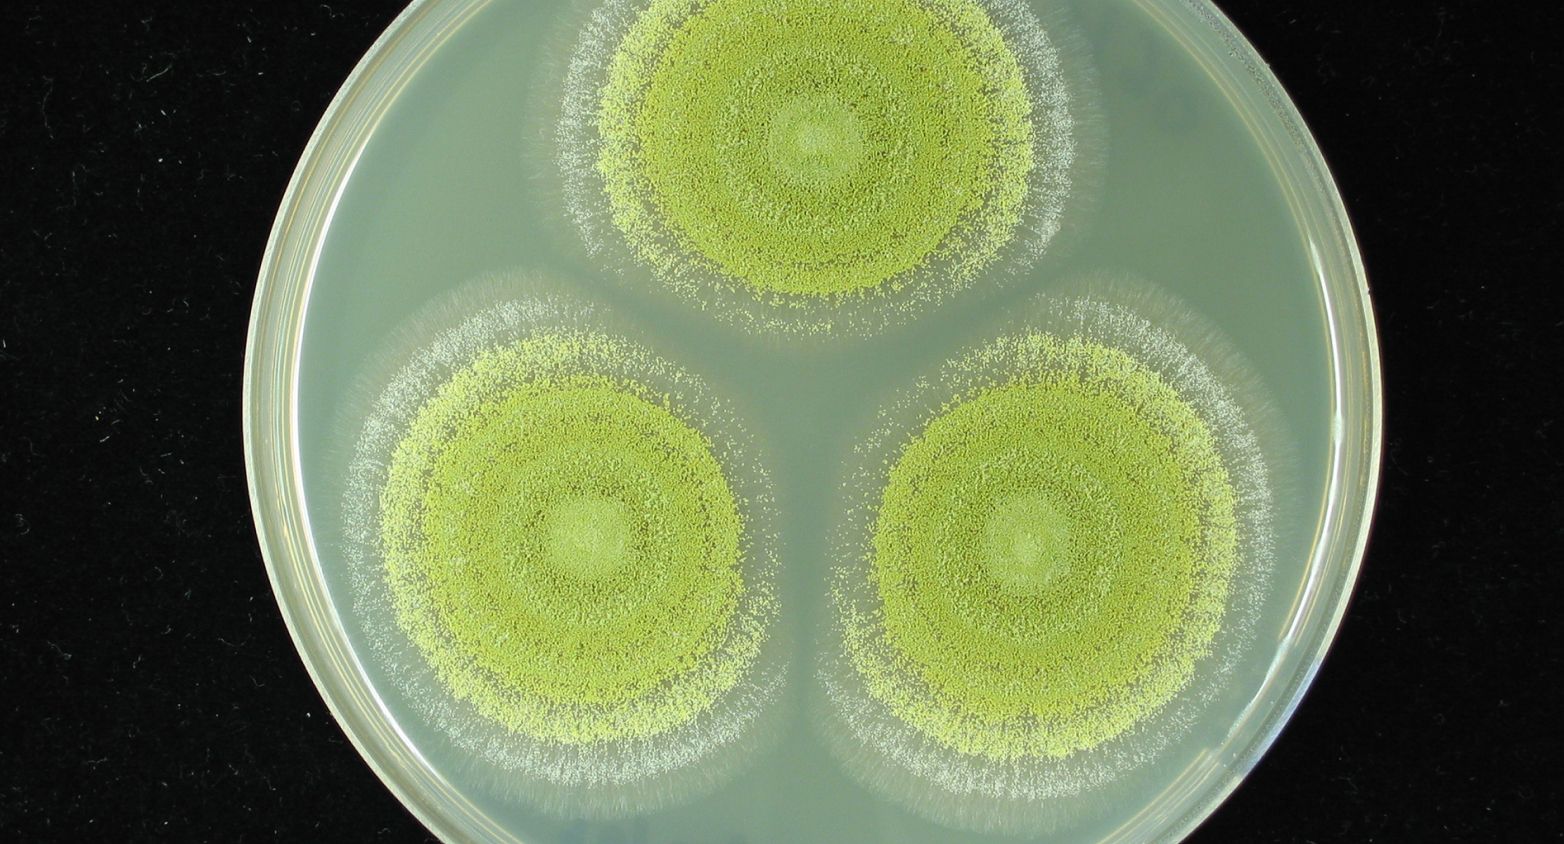
Fungi in a Petri dish

The Biological Resource Center of Institut Pasteur. The CRBIP is a transversal biobank infrastructure that includes microbial and human specimen collections of Institut Pasteur. The CRBIP receives, processes, maintains, characterizes and supplies biological resources globally, in compliance with health and environmental safety standards and under applicable laws and regulations.


The CRBIP has a unique position at national and international level, based on the combination of:
The CRBIP biological resources are integrated, processed, characterized, preserved and distributed in compliance with health and environmental biosafety and biosecurity standards and under applicable laws and regulations. Explore our large and diverse curated collections of microbial strains and human biological materials.

More than 15000 quality controled strains of bacteria.

More than 700 axenic strains of cyanobacteria.
100 quality controled strains of fungi and more coming.

More than 200000 samples in stock.
CHIP catalogue
More than 200 viruses in EVAg.
EVAg catalogue (European Virus Archive - Global)
Bacteriophages and microbiome collections are planned.
The new prices of the CIP and PCC strains are online.
Check under Ressources for more information

The National Center for Scientific and Technical Research (CNRST), in partnership with the Moroccan Ministry of Higher Education, Scientific Research and Innovation, the Biological Resource Center of the Institut Pasteur (CRBIP, France), and the National Research Institute for Agriculture, Food and the Environment (INRAE – France), organized the first Euro-African Congress dedicated to the valorization of microbial genetic resources, held from May 18 to 20, 2026, in Rabat.
Learn more about the Euro-African Microbial Resources CongressThe European Antimicrobial Resistance Genes Surveillance Network (EURGen-Net) is a key component of the genomic surveillance of multidrug-resistant bacteria and, as such, plays a vital role in public health. It is coordinated by the European Centre for Disease Prevention and Control (ECDC).
This European surveillance programme, based on epidemiology and whole-genome sequencing, aims, in particular, to determine the geographic distribution and population dynamics of multidrug-resistant clones and transmissible resistance elements to inform risk assessment, prevention and control policies and to support countries in developing technical capability and proficiency for genomic-based surveillance of multidrug-resistant bacteria with epidemic potential.
To address these public health challenges, EURGen-Net currently relies on the participation of national reference laboratories (CNR) or equivalent laboratories from 34 European countries.
For the past two years, the ECDC, as part of EURGen-Net, has been contracting the expertise of the Biological Resource Centre of the Institut Pasteur (CRBIP), headed by Fay Betsou. Recognized and commissioned as a specialist central biobank, the CRBIP centralises, purifies and analyses bacterial isolates from 34 European countries for two groups of pathogens: Acinetobacter baumannii and Klebsiella pneumoniae, bacteria that have become resistant to the carbapenem class of antibiotics and/or colistin (for more information, see the box dedicated to these bacterial strains). A third group, Pseudomonas aeruginosa, will follow in 2027.

The CRBIP contributes to clarification and guidance on sharing genetic resources and the Nagoya Protocol:
Faggionato D et al. Policy Briefing: from access to use—untangling the international legal frameworks that govern microbial resources. Sustainable Microbiology. Volume 3, Issue 1, 2026, qvag005
Faggionato D et al. Policy in practice: How to do the Nagoya Protocol: common misconceptions, challenges and best practices for access and benefit-sharing compliance. Sustainable Microbiology. Volume 3, Issue 2, 2026, qvag007

The PARADIGM kick-off meeting took place on the 6th October 2024 at the Saint-Antoine Hospital in Paris (AP-HP).
Within the PARADIGM project, the Collection of Institut Pasteur (CIP) will be responsible for compiling and managing this national biobank for bacteriophages and hosting bacterial strains. The project management office ( CRBIP-PMO) will be involved in CRBIP internal coordination. The Genome Informatics and Phylogenetics Expertise Group (GIPhy) will be responsible for bioinformatics quality control of the phages and their host strains.
The PARADIGM project is supported by the French government under the France 2030 program managed by the National Research Agency (ANR), reference ANR-24-PEBI-0005. The project was selected by the ANR via its Priority Research Programs and Equipment initiative on Biotherapies – PEPR Biothérapies.
Discover the project
The taxonomic characterization of two novel Cyanobacteriota species has been recently published in the International Journal of Systematic and Evolutionary Microbiology (IJSEM).
This polyphasic evaluation, conducted by members from the Collection of Cyanobacteria (PCC) and the group 'Genome Informatics & Phylogenetics' (GIPhy), has successfully shown that the strains Thalassoporum mexicanum PCC 7367(T) and Tumidithrix helvetica PCC 7403(T) represent novel species of the pseudanabaenalean families Thalassoporaceae and Pseudanabaenaceae, respectively.
Discover the articleAs part of valorization actions at CRBIP, the Genome Informatics and Phylogenetics (GIPhy) expertise group implemented large-scale bioinformatics strategies to reanalyze bacterial strains from CIP that have been sequenced since 2016. As a result, 463 of these new genome assemblies (mainly type strains) were publicly distributed to the scientific community.
Find the genome assemblies hereThe concept of “Target Specimen Profiles” (TSPs) for biobanks collecting specimen panels for diagnostic applications has been published.
A target specimen profile (TSP) corresponds to the required characteristics of the specimen panels needed to demonstrate that a diagnostic kit meets the target product profile (TPP). TSPs can guide biobanks in the prospective collection of sample panels to support the development and validation of diagnostics.
Ten examples of TSPs, specific for infectious diseases, are provided in the Supplementary Materials.
Discover the articleWe offer wet lab services for different types of biological resources, both microbial and human-origin. We also offer bioinformatics services for microbial resources.
The CRBIP accepts deposits of strains, and offers storage of your valuable or irreplaceable biological materials.
Processing of microbial or human specimens, preparation of molecular or cellular derivatives.
Authentication, quantification, phenotypic characterization, genomic taxonomy services
Strict Quality Assurance is a central part of our strategy. Our Quality Management System covers all biobanking processes and aims at fitness-for-purpose of the biological resources we are making available.

for any question to which you do not find the answer in the FAQ, don't hesitate to contact us, crbip-pmo@pasteur.fr
Access to our FAQ